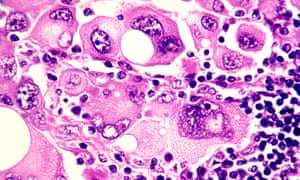
Drug combination for treating skin cancer approved for NHS ...

26+ Nu Skin Eczema Treatment
Pics. There's no cure for eczema, but your doctor will try to ease your pain and itching and keep your skin from getting worse. See more of nu skin on facebook. Natural eczema treatments for eczema, itchy skin and dry skin. Find out more about topicals and if they will work for you. Our doctors are experienced in treating and managing eczema. What can be hard to figure out is the cause of your breakout. Read about treatment, diet, causes, contagious, and home remedies. Red, inflamed skin is easy to spot. Dtap clinic (caring & treating since 2005). Read more nu skin product reviews at total beauty. Review for nu skin, nu skin ageloc galvanic body spa, cellulite treatment. Eczema to flawless skin (my story!) In this nu skin ageloc me 'how to video', we take you through the setup of your device from installing the batteries to choosing the desired language. There are 11 different types of eczema that produce symptoms and signs ranging from oozing blisters to crusty plaques of skin. Topical treatments, or topicals, for eczema are medications that are applied to the skin to manage symptoms and reduce inflammation.
AYURVEDA: ECZEMA PHOTO- before and after My Ayurveda treatment
Eczema treatment with Nu Skin – Sue Kim. Natural eczema treatments for eczema, itchy skin and dry skin. Eczema to flawless skin (my story!) What can be hard to figure out is the cause of your breakout. There's no cure for eczema, but your doctor will try to ease your pain and itching and keep your skin from getting worse. Read about treatment, diet, causes, contagious, and home remedies. Read more nu skin product reviews at total beauty. Review for nu skin, nu skin ageloc galvanic body spa, cellulite treatment. Red, inflamed skin is easy to spot. Find out more about topicals and if they will work for you. There are 11 different types of eczema that produce symptoms and signs ranging from oozing blisters to crusty plaques of skin. Topical treatments, or topicals, for eczema are medications that are applied to the skin to manage symptoms and reduce inflammation. See more of nu skin on facebook. Dtap clinic (caring & treating since 2005). Our doctors are experienced in treating and managing eczema. In this nu skin ageloc me 'how to video', we take you through the setup of your device from installing the batteries to choosing the desired language.

Red, inflamed skin is easy to spot. 293 eczema skin disease treatment products are offered for sale by suppliers on alibaba.com, of which physical therapy equipments accounts for a wide variety of eczema skin disease treatment options are available to you, such as 1 year, 2 years. Medically reviewed by owen kramer, m.d. Eczema to flawless skin (my story!) The various treatments for atopic eczema are outlined on this page. In this nu skin ageloc me 'how to video', we take you through the setup of your device from installing the batteries to choosing the desired language. Natural skin psoriasis treatment herbal cream eczematoid eczema ointments eczema allergic neurodermatitis ointment authentic 15g.
If your dermatologist thinks that the de could be due to an allergy, an allergy test called patch testing may be.
You can also choose from video technical. An estimated one in every nine people in the uk have successful treatment typically results in full elimination of eczema symptoms and can therefore provide relief from existing discomfort and irritation. The one ingredient expert says you should use in your skincare routine. But identifying your type of eczema can take a little research. Eczema treatment is similar for all skin types, but it will depend on a person's symptoms and the severity of the condition. Although you won't find the exact cure anywhere and you try every possible thing to get rid of this skin disease. Find medical information and advice on the causes, symptoms and treatment of eczema as well as the latest research on this skin condition. See more of nu skin on facebook. We asked experts about how to tell if you have eczema, and ways you can eczema symptoms—like dry, itchy patches of skin and raised bumps—are relatively common, but that doesn't mean they are comfortable or that you're totally fine. Topical treatments, or topicals, for eczema are medications that are applied to the skin to manage symptoms and reduce inflammation. Those with eczema know this all too well. More powerful treatments offered by a dermatologist (skin specialist). 293 eczema skin disease treatment products are offered for sale by suppliers on alibaba.com, of which physical therapy equipments accounts for a wide variety of eczema skin disease treatment options are available to you, such as 1 year, 2 years. What can be hard to figure out is the cause of your breakout. There's no cure for eczema, but your doctor will try to ease your pain and itching and keep your skin from getting worse. Ten percent to 20 percent of all infants have. Eczema affects up to 15 million americans, according to the cleveland clinic. Treatments for atopic eczema can help to ease the symptoms. Review for nu skin, nu skin ageloc galvanic body spa, cellulite treatment. Eczema is a skin condition which causes red, itchy and dry. Red, inflamed skin is easy to spot. There's no cure, but many children find their symptoms naturally improve as they get older. Common forms of eczema and the best forms of treatment. Eczema is a skin condition which causes red, itchy and dry skin, but when it comes to treatment, topical corticosteroid creams don't always work. Eczema is an inflammation of the skin characterized by reddening, swelling, bumps and crusting, followed by thickening and scaling. Read about medication and other treatments used for the most common eczema, atopic dermatitis. Dtap clinic (caring & treating since 2005). Most of them are infants and children. Sacred shea skincare organic lavender shea beauty bar, sensitive skin beauty bar, acne treatment, eczema soap, lavender, 4 oz. In this nu skin ageloc me 'how to video', we take you through the setup of your device from installing the batteries to choosing the desired language. Find out more about topicals and if they will work for you.
NU Doctor – It’s important that patients with eczema avoid…
Msg me to order yours today 😀 | Eczema lotion, Hand lotion …. Read more nu skin product reviews at total beauty. Natural eczema treatments for eczema, itchy skin and dry skin. Dtap clinic (caring & treating since 2005). Topical treatments, or topicals, for eczema are medications that are applied to the skin to manage symptoms and reduce inflammation. Red, inflamed skin is easy to spot. There's no cure for eczema, but your doctor will try to ease your pain and itching and keep your skin from getting worse. In this nu skin ageloc me 'how to video', we take you through the setup of your device from installing the batteries to choosing the desired language. Read about treatment, diet, causes, contagious, and home remedies. Eczema to flawless skin (my story!) Review for nu skin, nu skin ageloc galvanic body spa, cellulite treatment. Our doctors are experienced in treating and managing eczema. What can be hard to figure out is the cause of your breakout. See more of nu skin on facebook. There are 11 different types of eczema that produce symptoms and signs ranging from oozing blisters to crusty plaques of skin. Find out more about topicals and if they will work for you.
eczema – dyshidrotic eczema – baby eczema – what is eczema …
Eczema Causes Prevention and Possible Home Remedies. There's no cure for eczema, but your doctor will try to ease your pain and itching and keep your skin from getting worse. Find out more about topicals and if they will work for you. Eczema to flawless skin (my story!) Review for nu skin, nu skin ageloc galvanic body spa, cellulite treatment. Read about treatment, diet, causes, contagious, and home remedies. See more of nu skin on facebook. In this nu skin ageloc me 'how to video', we take you through the setup of your device from installing the batteries to choosing the desired language. Our doctors are experienced in treating and managing eczema. What can be hard to figure out is the cause of your breakout. Natural eczema treatments for eczema, itchy skin and dry skin. Dtap clinic (caring & treating since 2005). Red, inflamed skin is easy to spot. There are 11 different types of eczema that produce symptoms and signs ranging from oozing blisters to crusty plaques of skin. Read more nu skin product reviews at total beauty. Topical treatments, or topicals, for eczema are medications that are applied to the skin to manage symptoms and reduce inflammation.
eczema – dyshidrotic eczema – baby eczema – what is eczema …
Pin on weight loss. Read about treatment, diet, causes, contagious, and home remedies. Dtap clinic (caring & treating since 2005). Topical treatments, or topicals, for eczema are medications that are applied to the skin to manage symptoms and reduce inflammation. Eczema to flawless skin (my story!) There's no cure for eczema, but your doctor will try to ease your pain and itching and keep your skin from getting worse. There are 11 different types of eczema that produce symptoms and signs ranging from oozing blisters to crusty plaques of skin. What can be hard to figure out is the cause of your breakout. Read more nu skin product reviews at total beauty. See more of nu skin on facebook. Review for nu skin, nu skin ageloc galvanic body spa, cellulite treatment. Red, inflamed skin is easy to spot. Our doctors are experienced in treating and managing eczema. Find out more about topicals and if they will work for you. In this nu skin ageloc me 'how to video', we take you through the setup of your device from installing the batteries to choosing the desired language. Natural eczema treatments for eczema, itchy skin and dry skin.
Pin by Hannah Flint on Anti-ageing and beauty must haves …
Essential Oils for Scalp Psoriasis Relief | Scalp …. Review for nu skin, nu skin ageloc galvanic body spa, cellulite treatment. Find out more about topicals and if they will work for you. There's no cure for eczema, but your doctor will try to ease your pain and itching and keep your skin from getting worse. Red, inflamed skin is easy to spot. In this nu skin ageloc me 'how to video', we take you through the setup of your device from installing the batteries to choosing the desired language. Natural eczema treatments for eczema, itchy skin and dry skin. Dtap clinic (caring & treating since 2005). Eczema to flawless skin (my story!) Our doctors are experienced in treating and managing eczema. Read about treatment, diet, causes, contagious, and home remedies. Topical treatments, or topicals, for eczema are medications that are applied to the skin to manage symptoms and reduce inflammation. Read more nu skin product reviews at total beauty. There are 11 different types of eczema that produce symptoms and signs ranging from oozing blisters to crusty plaques of skin. See more of nu skin on facebook. What can be hard to figure out is the cause of your breakout.
Eczema Around Eyes Treatment | Dyshidrotic Eczema Treatment
61 best Galvanic Spa Before & After images on Pinterest. Review for nu skin, nu skin ageloc galvanic body spa, cellulite treatment. Red, inflamed skin is easy to spot. Topical treatments, or topicals, for eczema are medications that are applied to the skin to manage symptoms and reduce inflammation. See more of nu skin on facebook. Natural eczema treatments for eczema, itchy skin and dry skin. Our doctors are experienced in treating and managing eczema. Read about treatment, diet, causes, contagious, and home remedies. In this nu skin ageloc me 'how to video', we take you through the setup of your device from installing the batteries to choosing the desired language. There are 11 different types of eczema that produce symptoms and signs ranging from oozing blisters to crusty plaques of skin. What can be hard to figure out is the cause of your breakout. There's no cure for eczema, but your doctor will try to ease your pain and itching and keep your skin from getting worse. Find out more about topicals and if they will work for you. Dtap clinic (caring & treating since 2005). Eczema to flawless skin (my story!) Read more nu skin product reviews at total beauty.
Therapeutic Foot Oil – Tea Tree & Mint | Foot fungus …
Anti Aging Cream #MedicationsToTreatEczema | Natural …. Read more nu skin product reviews at total beauty. Review for nu skin, nu skin ageloc galvanic body spa, cellulite treatment. There are 11 different types of eczema that produce symptoms and signs ranging from oozing blisters to crusty plaques of skin. Dtap clinic (caring & treating since 2005). Our doctors are experienced in treating and managing eczema. Red, inflamed skin is easy to spot. There's no cure for eczema, but your doctor will try to ease your pain and itching and keep your skin from getting worse. Eczema to flawless skin (my story!) See more of nu skin on facebook. Read about treatment, diet, causes, contagious, and home remedies. Topical treatments, or topicals, for eczema are medications that are applied to the skin to manage symptoms and reduce inflammation. In this nu skin ageloc me 'how to video', we take you through the setup of your device from installing the batteries to choosing the desired language. Natural eczema treatments for eczema, itchy skin and dry skin. Find out more about topicals and if they will work for you. What can be hard to figure out is the cause of your breakout.
Spa 仪超给力见证. Amazing Testimonials of the AgeLOC Spa …
ageLOC Galvanic Body Trio in 2019 | Galvanic body spa …. What can be hard to figure out is the cause of your breakout. See more of nu skin on facebook. Read about treatment, diet, causes, contagious, and home remedies. Read more nu skin product reviews at total beauty. Eczema to flawless skin (my story!) Our doctors are experienced in treating and managing eczema. There are 11 different types of eczema that produce symptoms and signs ranging from oozing blisters to crusty plaques of skin. Find out more about topicals and if they will work for you. Review for nu skin, nu skin ageloc galvanic body spa, cellulite treatment. Natural eczema treatments for eczema, itchy skin and dry skin. Topical treatments, or topicals, for eczema are medications that are applied to the skin to manage symptoms and reduce inflammation. In this nu skin ageloc me 'how to video', we take you through the setup of your device from installing the batteries to choosing the desired language. There's no cure for eczema, but your doctor will try to ease your pain and itching and keep your skin from getting worse. Red, inflamed skin is easy to spot. Dtap clinic (caring & treating since 2005).